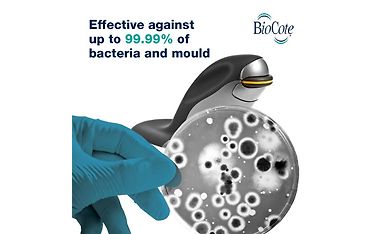
Kuva 6 / 13

Tuotteen kuvat ja videot
Hintatiedot
Hinta 149,99 €.149,99
Maksa myöhemmin Tilillä
Saatavuustiedot
Lähetettävissä2–3 viikkoa
Tilattavissa noutoon
Nouto Helsingin noutolokerikosta
0,00Saatavuus myymälän hyllyssä
Helsingin myymälän hyllyssä0 kpl
Hyllyssä olevia tuotteita ei voi varata tilaukseen
- Molempikätinen pystyhiiri
- S-koko sopii pienelle kädelle
- Ehkäisee hiirityöskentelyn rasitusvammoja
- Langaton-langallinen-bluetooth samassa hiiressä
- Antimikrobinen BioCote®-pinnoite